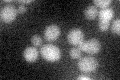
YBR264C
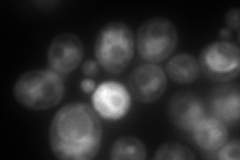
YBR264C
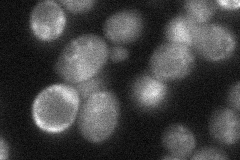
YBR264C
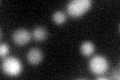
YBR264C
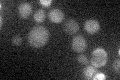
YBR264C

View description
GTP binding protein that contains the PEST signal sequence specific for proteolytic enzymes; may be involved in vesicular transport; overexpression leads to accumulation of Golgi-like cisternae with budding vesicles
Localization:
Intensity:
Fold change:
Significance:
-
C’ GFP library in SD
below threshold18.2 -
N' NOP1pr-GFP in SD

vacuole membrane102.265 -
N' TEF2pr-mCherry in SD
ER,vacuole194.677 -
N' NATIVEpr-GFP in SD
ambiguous,vacuole membrane32.3098 -
N' TEF2pr-VC and Cyto-VN in SD

cytosol,punctate39.5569 -
C’ GFP library in SD+DTT
cytosol22.591.24No -
C’ GFP library in SD+H2O2

cytosol17.650.96No -
C’ GFP library in Starvation Media
cytosol20.061.1No -
C’ GFP library on the background of Pup2-DaMP

below threshold -
C’ GFP library on the background of CCT mutant

below threshold16.78730.921868No
